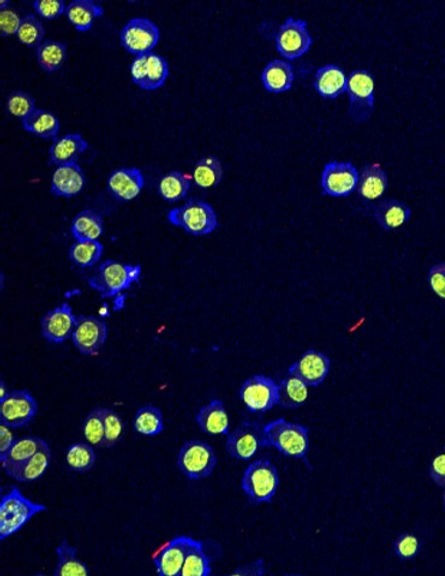
Biology

top of page

GRADE A TUTORING
Finding the right tutor can significantly impact a student's understanding of complex subjects like physics, chemistry, mathematics and programming. Our highly qualified tutors are available for your academic support.
Our Services

1 hr
From 45 Canadian dollars

1 hr
From 50 Canadian dollars
1 hr
From 50 Canadian dollars1 hr
50 Canadian dollars
1 hr
From 60 Canadian dollars
1 hr
From 45 Canadian dollars



1 hr
From 45 Canadian dollars

1 hr
From 40 Canadian dollars
bottom of page